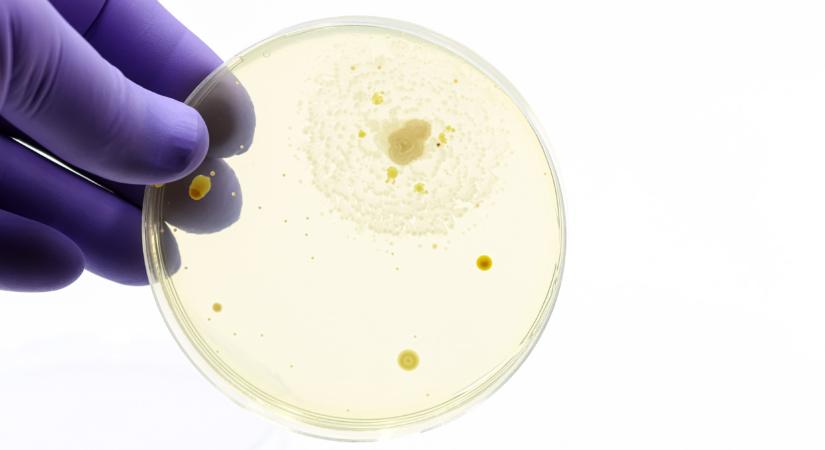
Borzasztó lista: egyre több a veszélyes élelmiszer Magyarországon

Borzasztó lista: egyre több a veszélyes élelmiszer Magyarországon
Idén sokkal több problémás élelmiszert kellett visszahívni, mint korábban - közölte a Nébih.

Hamarosan átirányítunk a teljes cikkhez → Agrárszektor
Idén sokkal több problémás élelmiszert kellett visszahívni, mint korábban - közölte a Nébih.
Hamarosan átirányítunk a teljes cikkhez → Agrárszektor